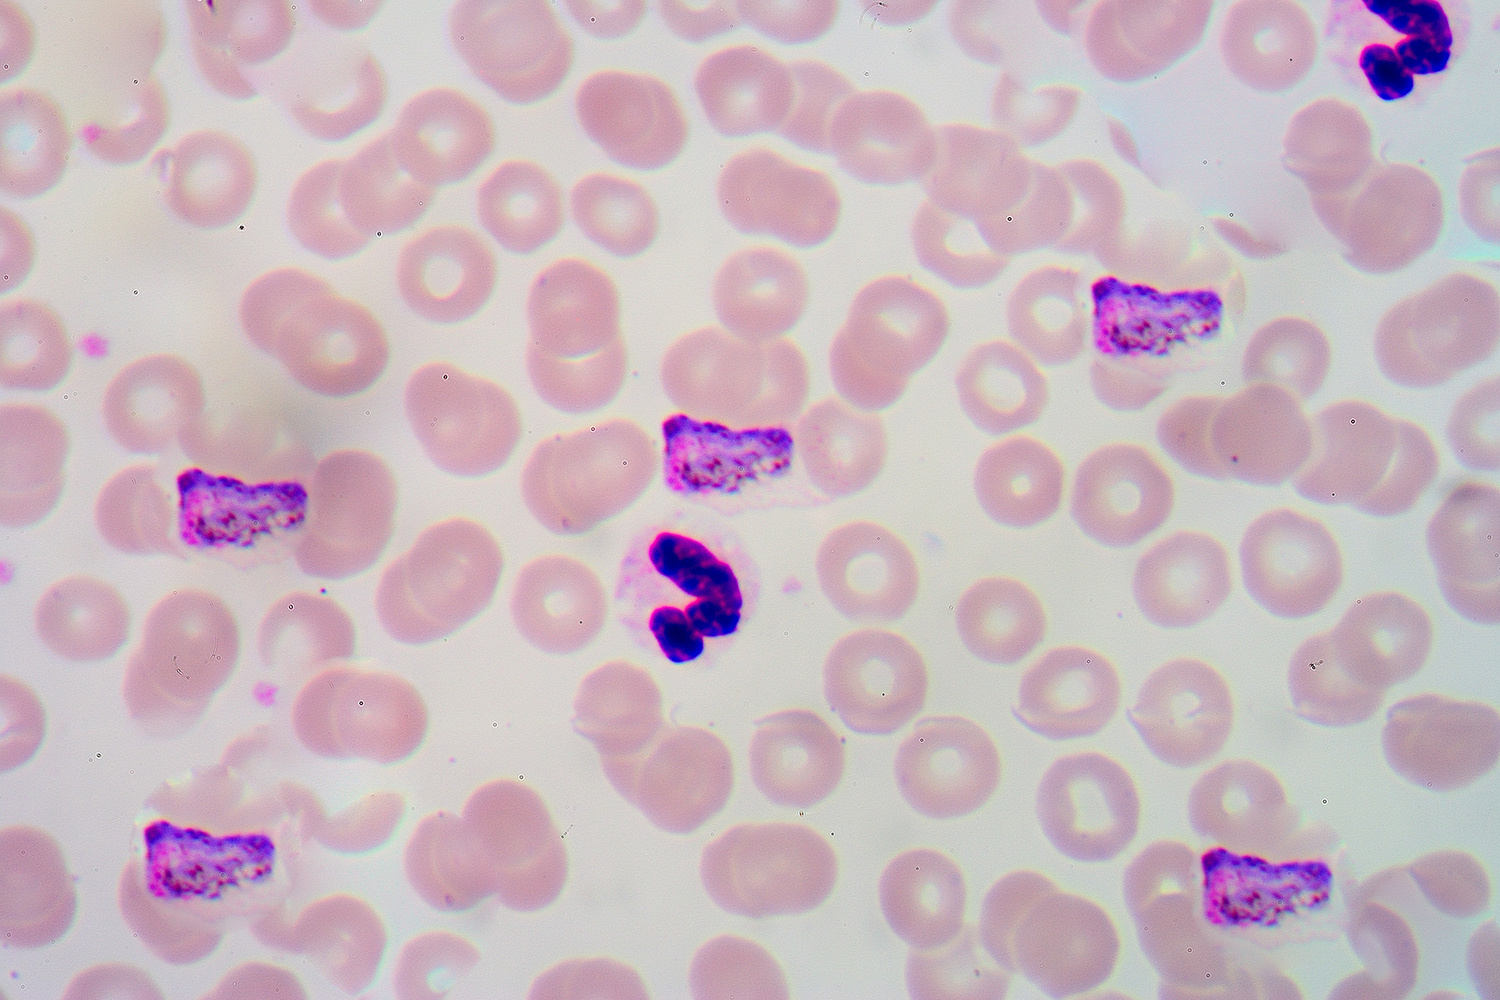
756191617869986.jpg

Малярия: симптомы, возбудители, лечение, советы врача
25 апреля отмечается Всемирный день борьбы с малярией. Его организовали для того, чтобы напомнить людям об этой опасной инфекционной болезни. Рассказываем, что нужно знать о малярии.

Статью прокомментировала и проверила Анна Цыганкова, старший врач-консультант медицинской компании BestDoctor
- Что такое малярия
- Возбудители
- Разновидности
- Симптомы
- Диагностика
- Лечение
- Прививка
- Профилактика
- Малярия в России
- Комментарий эксперта
Что такое малярия
Малярия — одно из самых распространенных инфекционных заболеваний в мире. Его вызывают паразиты-плазмодии, которых разносят малярийные комары. Инкубационный период заболевания может длиться от 11 дней до нескольких месяцев. Главный симптом — регулярные приступы тяжелой лихорадки, которые происходят раз в два-три дня. В тяжелых формах болезнь может приводить к опасным поражениям органов.
Еще 80 лет назад малярия была распространена по всему земному шару. Однако благодаря развитию экономики и медицины сегодня болезнь побеждена в половине стран мира и свирепствует лишь в жарких развивающихся странах. Ученые считают, что человечество сможет полностью победить малярию к 2050 году — правда, для этого придется тратить на борьбу с ней дополнительные $2 млрд в год.
По данным ВОЗ, ежегодно малярией заболевают около 228 млн человек, из которых 400 тыс. умирают. 94% случаев малярии регистрируются в Африке, их них половина — в шести странах: Нигерии, Конго, Танзании, Буркине-Фасо, Мозамбике и Нигере. Больше всего от малярии страдают дети от полугода до пяти лет, у которых полностью отсутствует иммунитет к болезни. На них приходится две трети смертей от малярии.
Нередко малярией заражаются туристы и путешественники. По данным ВОЗ, ежегодно около 10 тыс. человек привозят болезнь из зарубежных поездок.
Возбудители малярии
Болезнь переносят комары рода Anopheles, зараженные малярийными плазмодиями — простейшими паразитами, которые и выступают непосредственными возбудителями болезни. Малярийные комары обитают в основном на болотах и в мелких стоячих водоемах, в том числе в лужах. Многие страны избавились от малярии благодаря масштабным кампаниям по осушению болот.
Две сотни видов малярийных комаров можно встретить по всей планете, за исключением пустынь и территорий Крайнего Севера. В России распространен вид Anopheles Messeae. Однако он перестал переносить болезнь более 50 лет назад. Сегодня малярией можно заразиться лишь от азиатских и африканских видов малярийных комаров.
Сперва малярийный комар пьет кровь человека, зараженного малярией. В его кишечник попадают плазмодии. Затем он кусает другого человека и передает ему личинки паразитов. Те сначала попадают в печень, где растут и развиваются. Когда плазмодии становятся взрослыми, они проникают из печени в кровоток, после чего у человека проявляются первые симптомы малярии. Некоторые разновидности плазмодиев могут дремать в печени долгое время.
Также малярия может передаваться от человека к человеку без участия комаров: от матери к ребенку (очень редко), через переливание крови и при совместном использовании игл для инъекций.

Виды малярии
Из нескольких сотен малярийных плазмодий для человека опасны лишь пять. Каждый из них вызывает особый вид болезни.
Трехдневная малярия
Plasmodium vivax вызывает трехдневную малярию (vivax-малярию) — сравнительно легкую форму с длительным течением. Она характеризуется тем, что малярийные приступы лихорадки наступают каждые двое суток, нередко в одно и то же время дня, с 11 до 16 часов. Еще одна разновидность патогена — P. ovale — вызывает ovale-малярию, которая похожа на трехдневную.
P. Vivax распространен в Таджикистане, Афганистане, Пакистане и Непале, а также в Центральной Америке и северной части Южной Америки. Раньше именно этот вид плазмоидов был распространен в Европе и России. P. Ovale встречается в основном в Африке, там же, где и плазмодии, вызывающие тропическую лихорадку.
Четырехдневная малярия
P. malariae вызывает четырехдневную малярию, при которой приступы происходят каждые 70-72 часа. Эта форма не такая тяжелая, однако в редких случаях может вызывать серьезное повреждение почек — нефрологический синдром. Плазмодии этого типа могут скрыто жить в организме человека десятилетия даже после выздоровления. Они вызывают довольно редкий вид малярии, который встречается в Индии, Индонезии, Камбодже и Лаосе.
Тропическая малярия
P. falciparum вызывает тропическую малярию. Это наиболее опасная разновидность болезни, и при этом самая распространенная — на нее приходится более 90% заражений. Приступы происходят нерегулярно, а болезнь поражает сосуды, что может приводить сначала к гипоксии, а затем и к отказу органов. Этот вид болезни доминирует во всей Африке, а в таких странах, как Индия, Вьетнам и Таиланд он встречается примерно так же часто, как трехдневная малярия.
